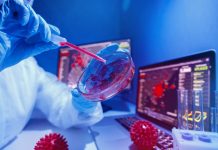
McGill AMR Centre: Tackling the global threat of antimicrobial resistance through collaborative and interdisciplinary research threat of AMR

Innovation News Network brings you the latest research and innovation news from the fields of science, environment, energy, critical raw materials, technology, and electric vehicles.
Bio-based products certification: EU webinar highlights collaborative path toward sustainability
Register now for the upcoming "Advancing Bio-Based Products Certification: A Collaborative Path Towards Sustainability," EU webinar.
New quantum algorithm eradicates the need for error correction
Researchers have implemented a quantum computing algorithm to estimate interatomic bond distances and ground state energies.
US announces $2.2bn boost for clean hydrogen hubs
The United Sates Department of Energy (DOE) has unveiled a groundbreaking $2.2 billion investment in two Regional Clean Hydrogen Hubs.
How the livestock sector can tackle AMR for a sustainable farming future
Dr Nataliya Roth of dsm-firmenich Animal Nutrition and Health discusses the need to tackle antimicrobial resistance in the livestock sector.
Driving global change at Thompson Rivers University’s research centres
Thompson Rivers University's research centres pioneer research to address critical global and local issues. Read more here.
McGill AMR Centre: Tackling the global threat of antimicrobial resistance through collaborative and interdisciplinary...
The McGill AMR Centre emphasises the urgency of reducing the global threat of AMR and highlights some of the Centre’s key work in this area.
From fission to fusion neutronics and multi-physics simulations at the University of Tennessee
Discover University of Tennessee research and training for the next generation of fusion nuclear engineering graduates.
Dynelectro and SolydEra partner to deliver 1 MW Solid Oxide Electrolyser by 2025
SolydEra and Dynelectro have teamed up to revolutionise green hydrogen with Solid Oxide Electrolyser innovation.
AvantGuard’s mission is to combat Candida auris and replace topical antibiotics
Candida auris is an urgent, worldwide threat to human health. AvantGuard has a three-pronged approach to combat that threat.
Plastic surge in North Pacific Garbage Patch alarms scientists
A study has revealed a disturbing acceleration in plastic pollution within the North Pacific Garbage Patch.